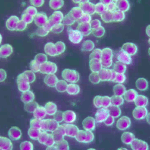
Fresh Blood
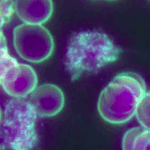
The Ballet of Immunity

Under the microscope, the immune system reveals its hidden magic. Here you can watch your own white blood cells — the body’s sentinels — moving, probing, and protecting in real time. Unlike red cells, which calmly carry oxygen, immune cells are alive with motion: stretching out pseudopods, sensing their surroundings, and engulfing debris or invaders. Some act as messengers, releasing powerful signals to call for reinforcements. Others recycle what they capture into raw materials to build new, healthy cells.
These videos offer a rare glimpse into the ballet of immunity — a living choreography of defence, repair, and renewal happening inside you every moment of every day.